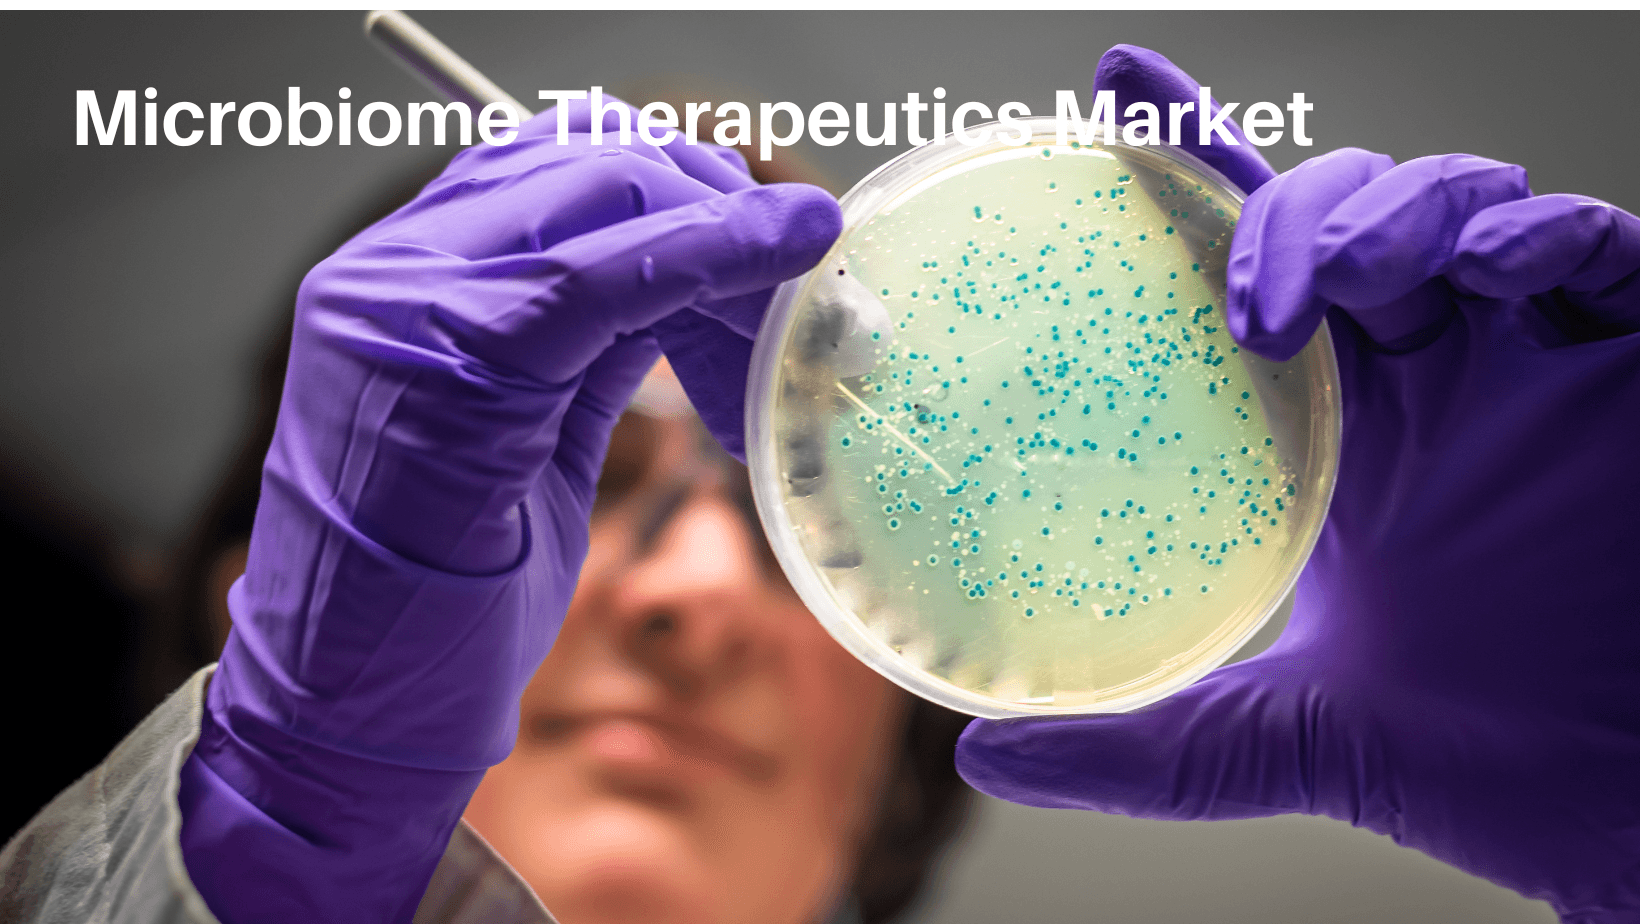
Microbiome Therapeutics Market Size, Growth and Forecast 2030

Microbiome Therapeutics Market Size, Growth and Forecast 2030
The latest market report published by Credence Research, Inc. “Global Microbiome Therapeutics Market: Growth, Future Prospects, and Competitive Analysis, 2022 – 2030”. The Global Microbiome Therapeutics Market generated revenue of around USD 310.2 million in 2022 and is anticipated to grow a CAGR of over 22.8% during the forecast period from 2023 to 2030 to reach around USD 1063.7 million in 2030.
Micro biome exploration has advanced our understanding of microbial colonization in health and disease subsets. The potential of gut microbes and their role in improving the human health is emerging in the present and upcoming future. Micro biome therapeutics are aimed at discovering the gut micro biome using additive, subtractive, or modulatory therapy with an application antibiotics, bacteriophages, and Others. This has developed the limitation of conventional therapeutics by providing personalized and sustainable treatment. The human micro biome lists all kind of microorganisms effect on the human body.
The global Microbiome Therapeutics market is bifurcated into the Type Outlook, Application Outlook and Geography. Based on type outlook, the market is categorized into FMT, and Microbiome Drugs. Based on application outlook, the global market is segmented into C. difficile, Crohn’s disease, Inflammatory Bowel Disease, Diabetes and Others.Based on geography, the market is segmented into North America, Europe, Asia Pacific, Latin America, and the Middle East and Africa.
In 2021, North America dominated the global microbiome therapeutics market and accounted for a major market revenue share value. Presence of the highly established research facilities for increasing the target population in the novel therapeutic advancement. The programme initiatives like the Canadian Microbiome Initiative (CMI) in Canada collaborating with the stakeholders allowing the research focus in the microbiome therapeutic development. Europe will be having significant growth as Germany is an emerging market in the microbiome therapeutics sector. The funding facilities in Europe will be facilitating the treatment adoption by the people in this region.
The microbiome—the collection of all microbes living in and on the human body—is a hot topic in healthcare. And for good reason: the microbiome has been linked to everything from gut health to immunity to brain function. Researchers are just beginning to scratch the surface of all the ways the microbiome affects our health, and there's already great interest in harnessing its power to treat various conditions. This is giving rise to a new field of medicine known as microbiome therapeutics.
Why Buy This Report-
· The report provides a qualitative and quantitative analysis of the global Microbiome Therapeutics market by segments, current trends, drivers, restraints, opportunities, challenges, and market dynamics with the historical period from 2016-2021, base year- 2022, and forecast period 2023-2030.
· The report contains information related to the competitive landscape, like how the key players in the market are operating at a global, regional, and country level.
· In-depth analysis of the global Microbiome Therapeutics market segmentation based on type outlook, application outlook.
· Major countries in each region with their import/export statistics
· The global Microbiome Therapeutics market report also includes analyzing the global, regional, and country levels, key market trends, significant players’ analysis, market growth strategies, and key application areas.
Browse Full Report: https://www.credenceresearch.com/report/microbiome-therapeutics-market
Visit: https://www.credenceresearch.com/
Browse Our Blog: https://www.linkedin.com/pulse/microbiome-therapeutics-market-size-worth-usd-10637-million-singh
Browse Our Blog: https://tealfeed.com/microbiome-therapeutics-market-size-expected-acquire-ph0rx
Browse Our Blog: https://medium.com/@priyanshi_97937/microbiome-therapeutics-market-is-expected-to-generate-a-revenue-of-usd-1063-7-million-by-2030-ad6d27d17748
Appreciate the creator